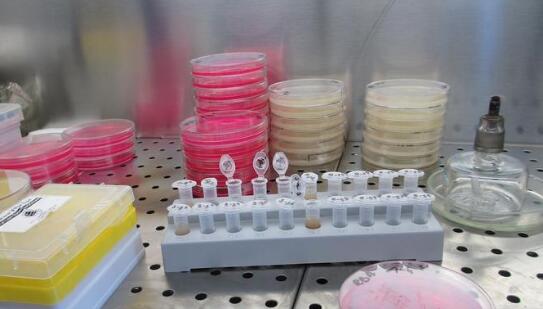
新闻图片2

上海邦景实业有限公司
9 年
手机商铺
商家活跃:
产品热度:
- NaN
- 0
- 0
- 2
- 2
全部产品
- 查看全部分类
- 菌种
- ATCC细胞
- elisa检测试剂盒
- 抗体
- 标准品
- 培养基
- 试剂盒
- 生化试剂
- elisa酶联免疫试剂盒
- 科研标准品
- 进口ELISA Kit
- RNA/DNA提取
- Sigma试剂
- 科研抗体
- 标准品、对照品
- 代理品牌
- 生物碱
- 黄酮
- 药物杂质及中间体
- 其它天然产物
- 蒽醌
- 其它醌类
- 甾体
- 查尔酮
- 氧杂蒽酮
- 木脂素
- 其它萜类
- 环烯醚萜
- 倍半萜
- 二萜
- 耗材仪器
- 其它酚类
- 三萜
- 香豆素
- 苯丙素
- 中药对照品
- 检测试剂盒
- PCR检测试剂盒
- 生物学试剂
- 细胞库
- 分析化学
- PCR试剂盒
- 耗材和仪器
- PCR鉴定试剂盒
- 进口抗体
- 原代细胞
- LAMP试剂盒
- 滴定缓冲溶液
- 植物提取对照品
- ELISA Kit
- 进口PCR试剂盒
- 进口ELISA检测试剂盒
- 抑制剂
- 快速检测试剂盒
- 荧光定量染料法PCR试剂盒
- 分子化合物
- PCR相关
- RNA相关产品
- 其他DNA/RNA聚合酶
- 核酸纯化
- PCR及RT-PCR相关
- DNA分子量标准
- 克隆载体及相关产品
- 恒温扩增系列
- 蛋白相关
- 核酸酶系列
- 核酸修饰酶系列
- miRNA检测系列
- 提取试剂盒
- 核酸纯化专题
- ELISA试剂盒
- 细胞系
- 蛋白
乳糖胆盐发酵培养基(高PH值)培养
询价
公司新闻/正文
影响培养基pH值因素及pH值测量
1713 人阅读发布时间:2023-12-26 14:27
大多数的培养基的配方都是依据标准来做的,例如国家标准、药典或者其他的国外标准。这些标准对培养基的pH值都有严格要求,一般都是控制在一个很小的范围。所以pH值对于培养基厂家的质量控制以及客户对培养基的验收,都是很重要的。

用于校准的缓冲液是非常精确的溶液,拥有固定的数值和精度。缓冲液瓶开封后,为了保证校准的准确性,要注意下面事项:
1. 第一次使用缓冲液时,在包装上标明日期,保证缓冲液包装的密封性。
2. 不要把使用过的缓冲液倒回原瓶,或把不同厂家的缓冲液混合在一起。
3. 常温下储存缓冲液,储存时避免阳光直射
4. 校准前请清洗电极,不要在原瓶中直接校准
5. 绝对不要使用过期的或污染的缓冲液
6. 缓冲液到期应及时更换新的缓冲液
药典对培养基pH的要求
中国药典2020年版四部9203 药品微生物实验室质量管理指导原则:
培养基若釆用不适当的加热和灭菌条件,有可能引起颜色变化、透明度降低、琼脂凝固力或pH值的改变。因此,培养基应采用验证的灭菌程序灭菌,培养基灭菌方法和条件,可通过无菌性试验和适用性检查(或灵敏度检查)试验进行验证。此外,对高压灭菌器的蒸汽循环系统也要加以验证,以保证在一定装载方式下的正常热分布。温度缓慢上升的高压灭菌器可能导致培养基的过热,过度灭菌可能会破坏绝大多数的细菌和真菌培养基促生长的质量。灭菌器中培养基的容积和装载方式也将影响加热的速度。此外还应关注灭菌后培养基体积的变化。
应确定每批培养基灭菌后的pH值(冷却至25℃左右测定)。若培养基处方中未列出pH值的范围,除非经验证表明培养基的pH值允许的变化范围很宽,否则,pH值的范围不能超过规定值±0.2。如需灭菌后进行调整,应使用灭菌或除菌的溶液。

培养基pH测定与调整
影响培养基pH的因素:
1.灭菌温度和时间
不同厂家或型号的高压蒸汽灭菌锅性能存在差异,灭菌锅整个灭菌过程的持续时间会导致培养基pH的变化不同。特别是对于一些含糖量较高又不含缓冲体系的培养基(如沙氏葡萄糖琼脂培养基、硫乙醇酸盐流体培养基等)影响更大,一些小型的灭菌锅灭菌较快,培养基中的成分变化较小,灭菌后的培养基pH相对比较稳定,而一些大型灭菌锅或灭菌柜则不相同,整个灭菌过程持续时间比较长,而且受装载量、内部物品分布等因素影响,灭菌后的培养基通常pH会偏低(主要是因为培养基中的糖类成分在高温下会出现焦化现象,温度越高,高温持续时间越久,焦化现象越明显,直观上表现为培养基的pH下降和颜色加深)。因此,在使用大型灭菌锅制备大量培养基时,应预先进行灭菌程序验证。
2.培养基的保温
一些琼脂培养,灭菌后可能不会立即使用,许多人会选择放50℃左右水浴保温,也有些人会选择直接在灭菌锅里保温。水浴保温相对影响较小,而灭菌锅的温度相对较高,保温过程易造成培养基内的糖类焦化,导致培养基pH下降。因此,灭完菌的培养基应及时从灭菌锅取出,在45~50℃左右保温一般不超过8h,可继续使用。
3.培养基的复融
已凝固的培养基,再次融化时需要加热处理,相当于增加了培养基的受热时间,复溶次数越多,培养基pH变化越大,同时也会导致琼脂的凝胶强度下降。因此,已凝固的培养基只允许复融一次使用。
4.培养基的溶解过程
大多数厂家的培养基标签上都写着灭菌前需进行加热溶解,加热后再进行灭菌的培养基溶解比较均匀,而且有利于灭菌过程中的热穿透,若灭菌前未进行加热溶解,易导致培养基pH变化不稳,特别是含琼脂的培养基,灭菌前不加热溶解易导致培养基分布不均匀,灭菌不彻底。含碳酸盐的培养基,灭菌前不加热易导致灭菌后的培养基pH偏低。
5.水质问题
若配制培养基使用的水质不佳,偏酸或偏碱,或含有一些离子,都有可能会导致培养基的pH出现偏差;一般均使用纯化水配制培养基。
6.培养基的成分
同样的灭菌温度和时间,同样的体积和装量的不同培养基,在灭菌后pH值变化不同,有的培养基pH值变化较多,有的培养基pH值变化较少。这是因为不同培养基的成分不尽相同,而不同的成分在灭菌过程中对培养基ph值有着不同的影响。糖类和蛋白胨是培养基中最常见的两种重要成分,那么这两种成分分别对培养基灭菌后pH值有着什么样的影响呢?
糖类,例如葡萄糖、乳糖等作为碳源被微生物所利用。糖类在高温条件下会产生有机酸使培养基pH值下降。一般情况下,培养基含糖量越高,灭菌后pH值下降越多。如果过度灭菌pH值变化会更加明显。同时,糖类在高温灭菌时容易焦化,使培养基颜色加深。
蛋白胨一般作为培养基氮源,为微生物的生长提供营养物质。蛋白胨在培养基灭菌时还能对培养基的pH值变化起到一定的缓冲作用。一般含胨量高的培养基,灭菌前后pH值变化相对较小。
若培养基成分中含有缓冲剂,如磷酸氢二钾等,也可以减少培养基灭菌前后pH值的变化。
另外有些培养基在灭菌后需添加一些营养成分增强营养或增加选择性,一些添加剂会对培养基的pH造成较大影响,如L-半胱氨酸盐酸盐酸性较强,加入培养基后会导致pH下降,因此应预先对培养基的pH进行调整,确保加入特定成分后的培养基pH依然在合格范围内。
7.测量温度
在标准中规定测定培养基的pH应以25℃为准,同一培养基在不同温度下测得的pH值也会有一定差异,大多数没有缓冲体系的营养类培养基pH随着温度降低而升高。培养基灭菌之后未完全冷却时,测量的pH值一般会偏低,这是由于温度升高时溶液中的游离离子数增多,测得的pH值较低;反之,当温度降低时游离离子数减少,测得的pH值较高。测量温度不对也会导测量的pH出现偏差,有些pH计虽然有温度补偿功能,但是这个模式并不能完全适用于培养基的测定,因此必须要在25℃时测定培养基的pH。
实验室中,细胞培养对培养基的pH有一定的要求,培养基pH值的测量:
1、校准:
首先在测量pH值时,我们都会对pH计进行一个校准工作,它的校准准确率对后续的测量有很大影响。pH电极需要有规律的进行校准。每天至少校准一次,是最恰当的。
由于每支电极都有其特征性的零点和斜率,为了得到可靠和精确的结果,最少两点校准是必不可少的。当要测量大范围的pH值时,则需要进行至少3点校准。大多数的pH仪表可以进行3-5点校准。
同时所测量的样品pH值落在所选择标准液范围之内也是非常重要的。
在电极进行校准时,最好等待缓冲液温度在标示温度下校准,这样测出的pH值才是缓冲液标示的值,比如pH 6.86和pH9.12的缓冲液是表示25℃下的pH值,那么你在20℃进行校准,显示的就不是6.86或者9.12。不过一般厂家都会附送一张缓冲液在不同温度下测的pH值。
2、培养基pH值的测量:
培养基按形态可以分为固体培养基和液体培养基。液体培养基可以选择普通液体的pH电极,固体培养基选择对应的固体pH电极,比如针对凝胶表面的平头电极。如果固体培养基用液体的pH电极测量,得出的结果是没有参考价值的。
首先在配置培养基的过程中,一定要注意配制用水一般用蒸馏水或者去离子水。否则可能对之后的pH值有影响。
其次,按照培养基厂家使用说明配置灭菌。一般培养基外包装标签上的pH标识表示灭菌后25℃测的pH值,所以液体培养基要待溶液温度达到25℃时测量培养基的pH值,固体培养基等其凝固后再用专用的固体pH电极测量,同时测量的温度也要在25度。
这里有些人可能会说我们的pH计有自动温补功能,是不是可以不用等到25度就可以测量?
这里需要注意的是自动温补功能只能补偿电极本身,并不能补充待测溶液的温度,所以培养基标准要求在25℃测量,那待测培养基溶液温度就要控制在25℃左右再测。
3、维护:
每次测量后用去离子水冲洗电极,切勿用纸擦拭电极。纸张粗糙的表面会刮划并损坏pH敏感玻璃上的凝胶层,并且会在电极上产生静电电荷。静电电荷会导致测量信号非常不稳定。
测量间隙或电极短时不用,电极需要储存在盛有专用的电极储存液,或电解液(如:3mol/L KCl)或缓冲液pH4或pH7的容器中。确保容器中电解液液面低于电极中填充液的液面。

用于校准的缓冲液是非常精确的溶液,拥有固定的数值和精度。缓冲液瓶开封后,为了保证校准的准确性,要注意下面事项:
1. 第一次使用缓冲液时,在包装上标明日期,保证缓冲液包装的密封性。
2. 不要把使用过的缓冲液倒回原瓶,或把不同厂家的缓冲液混合在一起。
3. 常温下储存缓冲液,储存时避免阳光直射
4. 校准前请清洗电极,不要在原瓶中直接校准
5. 绝对不要使用过期的或污染的缓冲液
6. 缓冲液到期应及时更换新的缓冲液
药典对培养基pH的要求
中国药典2020年版四部9203 药品微生物实验室质量管理指导原则:
培养基若釆用不适当的加热和灭菌条件,有可能引起颜色变化、透明度降低、琼脂凝固力或pH值的改变。因此,培养基应采用验证的灭菌程序灭菌,培养基灭菌方法和条件,可通过无菌性试验和适用性检查(或灵敏度检查)试验进行验证。此外,对高压灭菌器的蒸汽循环系统也要加以验证,以保证在一定装载方式下的正常热分布。温度缓慢上升的高压灭菌器可能导致培养基的过热,过度灭菌可能会破坏绝大多数的细菌和真菌培养基促生长的质量。灭菌器中培养基的容积和装载方式也将影响加热的速度。此外还应关注灭菌后培养基体积的变化。
应确定每批培养基灭菌后的pH值(冷却至25℃左右测定)。若培养基处方中未列出pH值的范围,除非经验证表明培养基的pH值允许的变化范围很宽,否则,pH值的范围不能超过规定值±0.2。如需灭菌后进行调整,应使用灭菌或除菌的溶液。
培养基pH测定与调整
影响培养基pH的因素:
1.灭菌温度和时间
不同厂家或型号的高压蒸汽灭菌锅性能存在差异,灭菌锅整个灭菌过程的持续时间会导致培养基pH的变化不同。特别是对于一些含糖量较高又不含缓冲体系的培养基(如沙氏葡萄糖琼脂培养基、硫乙醇酸盐流体培养基等)影响更大,一些小型的灭菌锅灭菌较快,培养基中的成分变化较小,灭菌后的培养基pH相对比较稳定,而一些大型灭菌锅或灭菌柜则不相同,整个灭菌过程持续时间比较长,而且受装载量、内部物品分布等因素影响,灭菌后的培养基通常pH会偏低(主要是因为培养基中的糖类成分在高温下会出现焦化现象,温度越高,高温持续时间越久,焦化现象越明显,直观上表现为培养基的pH下降和颜色加深)。因此,在使用大型灭菌锅制备大量培养基时,应预先进行灭菌程序验证。
2.培养基的保温
一些琼脂培养,灭菌后可能不会立即使用,许多人会选择放50℃左右水浴保温,也有些人会选择直接在灭菌锅里保温。水浴保温相对影响较小,而灭菌锅的温度相对较高,保温过程易造成培养基内的糖类焦化,导致培养基pH下降。因此,灭完菌的培养基应及时从灭菌锅取出,在45~50℃左右保温一般不超过8h,可继续使用。
3.培养基的复融
已凝固的培养基,再次融化时需要加热处理,相当于增加了培养基的受热时间,复溶次数越多,培养基pH变化越大,同时也会导致琼脂的凝胶强度下降。因此,已凝固的培养基只允许复融一次使用。
4.培养基的溶解过程
大多数厂家的培养基标签上都写着灭菌前需进行加热溶解,加热后再进行灭菌的培养基溶解比较均匀,而且有利于灭菌过程中的热穿透,若灭菌前未进行加热溶解,易导致培养基pH变化不稳,特别是含琼脂的培养基,灭菌前不加热溶解易导致培养基分布不均匀,灭菌不彻底。含碳酸盐的培养基,灭菌前不加热易导致灭菌后的培养基pH偏低。
5.水质问题
若配制培养基使用的水质不佳,偏酸或偏碱,或含有一些离子,都有可能会导致培养基的pH出现偏差;一般均使用纯化水配制培养基。
6.培养基的成分
同样的灭菌温度和时间,同样的体积和装量的不同培养基,在灭菌后pH值变化不同,有的培养基pH值变化较多,有的培养基pH值变化较少。这是因为不同培养基的成分不尽相同,而不同的成分在灭菌过程中对培养基ph值有着不同的影响。糖类和蛋白胨是培养基中最常见的两种重要成分,那么这两种成分分别对培养基灭菌后pH值有着什么样的影响呢?
糖类,例如葡萄糖、乳糖等作为碳源被微生物所利用。糖类在高温条件下会产生有机酸使培养基pH值下降。一般情况下,培养基含糖量越高,灭菌后pH值下降越多。如果过度灭菌pH值变化会更加明显。同时,糖类在高温灭菌时容易焦化,使培养基颜色加深。
蛋白胨一般作为培养基氮源,为微生物的生长提供营养物质。蛋白胨在培养基灭菌时还能对培养基的pH值变化起到一定的缓冲作用。一般含胨量高的培养基,灭菌前后pH值变化相对较小。
若培养基成分中含有缓冲剂,如磷酸氢二钾等,也可以减少培养基灭菌前后pH值的变化。
另外有些培养基在灭菌后需添加一些营养成分增强营养或增加选择性,一些添加剂会对培养基的pH造成较大影响,如L-半胱氨酸盐酸盐酸性较强,加入培养基后会导致pH下降,因此应预先对培养基的pH进行调整,确保加入特定成分后的培养基pH依然在合格范围内。
7.测量温度
在标准中规定测定培养基的pH应以25℃为准,同一培养基在不同温度下测得的pH值也会有一定差异,大多数没有缓冲体系的营养类培养基pH随着温度降低而升高。培养基灭菌之后未完全冷却时,测量的pH值一般会偏低,这是由于温度升高时溶液中的游离离子数增多,测得的pH值较低;反之,当温度降低时游离离子数减少,测得的pH值较高。测量温度不对也会导测量的pH出现偏差,有些pH计虽然有温度补偿功能,但是这个模式并不能完全适用于培养基的测定,因此必须要在25℃时测定培养基的pH。
实验室中,细胞培养对培养基的pH有一定的要求,培养基pH值的测量:
1、校准:
首先在测量pH值时,我们都会对pH计进行一个校准工作,它的校准准确率对后续的测量有很大影响。pH电极需要有规律的进行校准。每天至少校准一次,是最恰当的。
由于每支电极都有其特征性的零点和斜率,为了得到可靠和精确的结果,最少两点校准是必不可少的。当要测量大范围的pH值时,则需要进行至少3点校准。大多数的pH仪表可以进行3-5点校准。
同时所测量的样品pH值落在所选择标准液范围之内也是非常重要的。
在电极进行校准时,最好等待缓冲液温度在标示温度下校准,这样测出的pH值才是缓冲液标示的值,比如pH 6.86和pH9.12的缓冲液是表示25℃下的pH值,那么你在20℃进行校准,显示的就不是6.86或者9.12。不过一般厂家都会附送一张缓冲液在不同温度下测的pH值。
2、培养基pH值的测量:
培养基按形态可以分为固体培养基和液体培养基。液体培养基可以选择普通液体的pH电极,固体培养基选择对应的固体pH电极,比如针对凝胶表面的平头电极。如果固体培养基用液体的pH电极测量,得出的结果是没有参考价值的。
首先在配置培养基的过程中,一定要注意配制用水一般用蒸馏水或者去离子水。否则可能对之后的pH值有影响。
其次,按照培养基厂家使用说明配置灭菌。一般培养基外包装标签上的pH标识表示灭菌后25℃测的pH值,所以液体培养基要待溶液温度达到25℃时测量培养基的pH值,固体培养基等其凝固后再用专用的固体pH电极测量,同时测量的温度也要在25度。
这里有些人可能会说我们的pH计有自动温补功能,是不是可以不用等到25度就可以测量?
这里需要注意的是自动温补功能只能补偿电极本身,并不能补充待测溶液的温度,所以培养基标准要求在25℃测量,那待测培养基溶液温度就要控制在25℃左右再测。
3、维护:
每次测量后用去离子水冲洗电极,切勿用纸擦拭电极。纸张粗糙的表面会刮划并损坏pH敏感玻璃上的凝胶层,并且会在电极上产生静电电荷。静电电荷会导致测量信号非常不稳定。
测量间隙或电极短时不用,电极需要储存在盛有专用的电极储存液,或电解液(如:3mol/L KCl)或缓冲液pH4或pH7的容器中。确保容器中电解液液面低于电极中填充液的液面。

